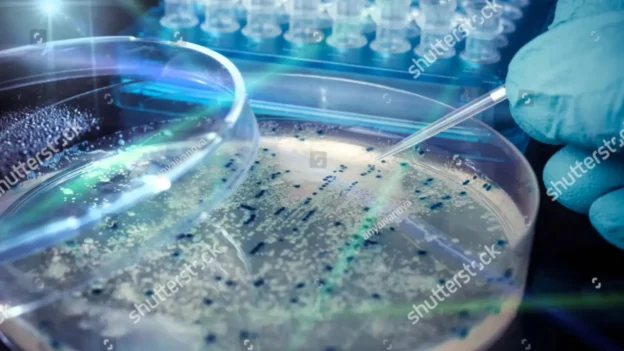
placa-de-petri-con-colonias-bacterianas-experimento-científico-

Traditional plastics have proven to be extremely useful, but they have also become a persistent environmental problem. The need for biodegradable and bio-based alternatives has motivated scientists around the world to search for new solutions.
Now, a group of bioengineers at Kobe University’s Kobe University has taken a decisive step forward by enabling modified bacteria to produce PDCA, a compound with properties superior to PET, efficiently and without generating waste.
The biodegradable alternative that could redefine the plastics industry
PDCA, or pyridinedicarboxylic acid, is a molecule with high potential to replace PET, which is widely used in textiles and packaging. Its great advantage lies in the fact that it is biodegradable and, unlike other bioplastics, can achieve levels of mechanical performance and stability comparable to those of conventional plastics.
Unlike other strategies that use biochemical pathways limited to carbon, hydrogen and oxygen, Kobe’s team incorporated enzymes that allow nitrogen to be assimilated during biosynthesis. This approach expanded the range of compounds possible through microbial synthesis, opening the door to new environmentally friendly plastic materials.
Redesigned E. coli bacteria for clean and efficient production
The team led by bioengineer Tanaka Tsutomu succeeded in genetically modifying E. coli strains to transform glucose into PDCA without generating byproducts. This breakthrough enables cleaner large-scale production than purely chemical methods, which often involve unselective reactions and unwanted waste.
Tanaka emphasized that this methodology not only lays the groundwork for the industrial application of PDCA, but also represents an expansion of the repertoire of biofabrication, allowing the exploration of new types of sustainable materials that integrate underutilized elements such as nitrogen.
Scalability and future projections for the biodegradable alternative
According to the researchers, the next step will be to optimize the yield in bioreactors to scale up the process in an industrially viable manner. The possibility of producing significant quantities of this biodegradable alternative to PET represents a turning point in the development of high-performance biodegradable plastics.
The Kobe team believes that every technical hurdle represents an opportunity for improvement and that the use of bacteria as synthesis platforms offers an adaptable and sustainable model for the future of materials.
This milestone positions PDCA as a strong candidate within the field of biofabricated materials and marks a new direction for metabolic engineering-driven green plastics research.
Source: Kobe University